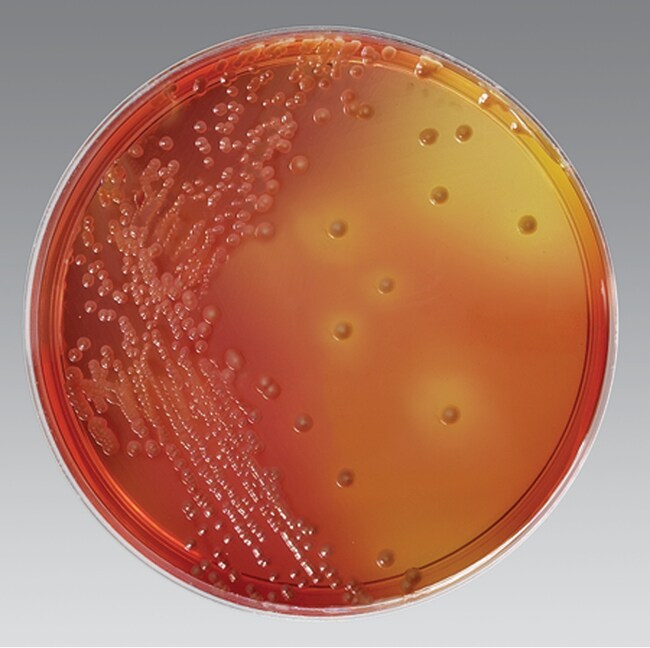
洋葱博克霍尔德菌琼脂 (USP 60) 500g

Search
Thermo Scientific™
Burkholderia cepacia Sel Agar (USP 60) 500g
Compliance to the USP 60 regulations for B. cepacia complex made simple
Catalog number R452642
Price (CNY)
-
Burkholderia cepacia medium (USP 60) is recommended for the qualitative procedures for the selective and differential isolation of B. cepacia complex in products, especially those for inhalation use of non-sterile acqueous preparations for oral, oromucosal, cutaneous or nasal use.
Confidently detect the presence of B. cepacia in nonsterile medicine with a complete workflow for USP 60 requirements which satisfies all regulations.
- Compliant formulation according to USP 60
- Quality tested to meet USP 60 specifically for Pharma customers
- Part of a complete workflow which include DCM and QCO
For Laboratory Use
For Laboratory Use
Specifications
DescriptionBurkholderia cepacia Selective agar (USP 60)
For Use With (Application)Pharmaceutical testing of non-sterile products used for nasal inhalation
Format500g Pot
Quantity500 g
Regulatory StatusLab use only
Product TypeAgar
Unit SizeEach